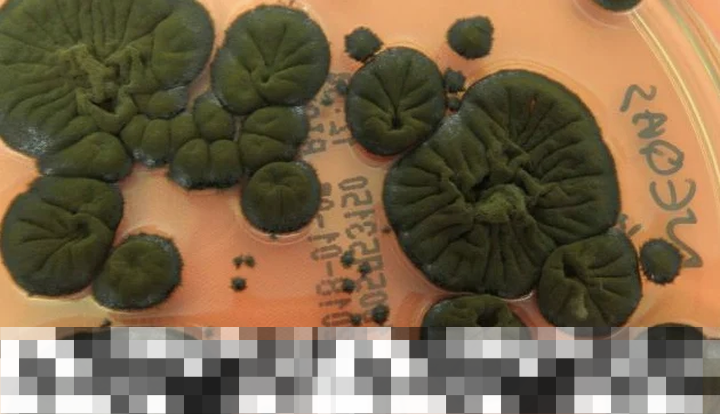

Jamur Chernobyl Ubah Radiasi Menjadi Sumber Energi Terbarukan yang Menjanjikan
Zona eksklusi Chernobyl, yang dikenal sebagai lokasi bencana nuklir terburuk dalam sejarah, menyimpan banyak misteri. Salah satunya adalah penemuan jamur hitam bernama Cladosporium sphaerospermum, yang menunjukkan kemampuan luar biasa untuk bertahan dan bahkan memanfaatkan paparan radiasi yang ekstrem. Temuan ini tidak hanya mengubah cara kita memahami kemampuan adaptasi kehidupan, tetapi juga memberikan harapan baru dalam pengembangan energi terbarukan. Dengan potensi untuk mengubah radiasi menjadi sumber energi yang berguna, jamur ini bisa jadi kunci dalam menghadapi tantangan energi di masa depan.
Keajaiban Jamur Cladosporium sphaerospermum
Jamur yang ditemukan di Chernobyl ini memiliki kemampuan unik untuk tumbuh subur di lingkungan dengan tingkat radiasi yang sangat tinggi. Keberadaannya di area yang terkena dampak bencana nuklir pada tahun 1986 menunjukkan bahwa kehidupan dapat beradaptasi bahkan di tempat paling tidak bersahabat. Penelitian awal menunjukkan bahwa pigmen melanin yang ada dalam jamur ini berfungsi untuk menyerap radiasi ionisasi, yang biasanya berbahaya bagi sel-sel kehidupan.
Peran Melanin dalam Penyerapan Radiasi
Melanin, pigmen yang memberikan warna pada banyak organisme, tampaknya memainkan peran penting dalam kemampuan jamur ini untuk bertahan hidup. Penelitian menunjukkan bahwa pigmen ini dapat menyerap radiasi berbahaya dan mengubahnya menjadi energi yang dapat digunakan. Hal ini menimbulkan pertanyaan menarik: apakah jamur ini sebenarnya dapat “memanen” radiasi?
- Jamur ini tumbuh di area dengan radiasi tinggi.
- Melanin berfungsi menyerap radiasi ionisasi.
- Radiasi yang diserap diubah menjadi energi.
- Penemuan ini membuka pintu untuk penelitian lebih lanjut.
- Jamur ini mampu beradaptasi dengan lingkungan ekstrem.
Mekanisme Energi Jamur: Mirip Fotosintesis
Proses yang digunakan oleh Cladosporium sphaerospermum untuk mengubah radiasi menjadi energi memiliki kemiripan dengan fotosintesis pada tumbuhan. Namun, alih-alih menggunakan cahaya matahari, jamur ini memanfaatkan radiasi sebagai sumber energinya. Temuan ini menarik perhatian ketika jamur ini diuji dalam kondisi luar angkasa, khususnya di Stasiun Luar Angkasa Internasional (ISS).
Eksperimen di Luar Angkasa
Dalam eksperimen tersebut, jamur ini terbukti efektif dalam mengurangi paparan radiasi. Sensor yang digunakan menunjukkan bahwa tingkat radiasi yang berhasil diserap oleh jamur jauh lebih rendah dibandingkan dengan area di sekitarnya yang tidak terpapar jamur. Hal ini menunjukkan potensi luar biasa jamur sebagai pelindung radiasi alami.
- Jamur ini diuji di Stasiun Luar Angkasa Internasional.
- Hasil menunjukkan pengurangan radiasi yang signifikan.
- Jamur dapat berfungsi sebagai pelindung untuk astronaut.
- Penemuan ini membuka peluang untuk misi luar angkasa di masa depan.
- Penggunaan jamur dalam perlindungan radiasi dapat menjadi solusi inovatif.
Tantangan dalam Penelitian Jamur Chernobyl
Walaupun kemampuan luar biasa jamur ini menarik perhatian, para ilmuwan masih berusaha memahami mekanisme pasti di balik proses ini. Tim peneliti yang dipimpin oleh Nils Averesch dari Stanford University mengingatkan bahwa radiosintesis yang sebenarnya masih perlu dibuktikan. Mereka menekankan pentingnya penelitian lebih lanjut untuk memahami apakah jamur ini benar-benar dapat menghasilkan energi dari radiasi seperti yang diharapkan.
Potensi Aplikasi Jamur dalam Berbagai Bidang
Jika kemampuan Cladosporium sphaerospermum dapat dimanfaatkan secara efektif, potensi aplikasinya sangat besar. Beberapa manfaat potensialnya meliputi:
- Peningkatan perlindungan radiasi bagi astronaut.
- Pengembangan teknologi baru dalam pengelolaan limbah nuklir.
- Penggunaan jamur sebagai sumber energi terbarukan.
- Penerapan dalam misi luar angkasa jangka panjang.
- Pemanfaatan dalam bidang bioteknologi dan penelitian lingkungan.
Menggali Lebih Dalam: Penelitian di Masa Depan
Keunikan jamur Chernobyl ini membuka babak baru dalam penelitian biologi dan potensi pemanfaatan sumber daya alam. Pengetahuan yang didapat dari penelitian ini tidak hanya memberikan wawasan baru tentang kemampuan adaptasi kehidupan, tetapi juga dapat berkontribusi pada solusi energi yang lebih berkelanjutan. Dengan berlanjutnya penelitian, kita dapat berharap untuk menemukan cara baru dalam menghadapi tantangan energi global.
Peran Kolaborasi dalam Penelitian
Pentingnya kolaborasi antara ilmuwan dari berbagai disiplin ilmu tidak dapat dikesampingkan. Penelitian lanjutan mengenai jamur Chernobyl ini memerlukan kontribusi dari biologi, fisika, dan bidang lainnya untuk mengungkap lebih banyak tentang potensi luar biasa yang dimilikinya.
- Kolaborasi antar disiplin ilmu sangat penting.
- Penelitian memerlukan pendekatan holistik.
- Diskusi dan berbagi informasi dapat mempercepat penemuan.
- Kerjasama internasional dapat membuka peluang baru.
- Penting untuk memahami dampak lingkungan dari penggunaan jamur.
Kesimpulan yang Menjanjikan
Cladosporium sphaerospermum adalah contoh nyata dari betapa menawannya dan misteriusnya alam. Meskipun tantangan penelitian masih ada, potensi yang dimiliki jamur ini untuk mengubah radiasi menjadi energi terbarukan memberikan harapan baru untuk masa depan. Dengan penelitian yang terus berlanjut, kita mungkin dapat menemukan solusi inovatif untuk masalah energi yang dihadapi dunia saat ini.
➡️ Baca Juga: Siaran Langsung Leg 2 Dewa United Melawan Manila Digger di AFC Challenge League Ditayangkan di RCTI
➡️ Baca Juga: Denza B5 Segera Meluncur di Pasar Indonesia, Kapan?





